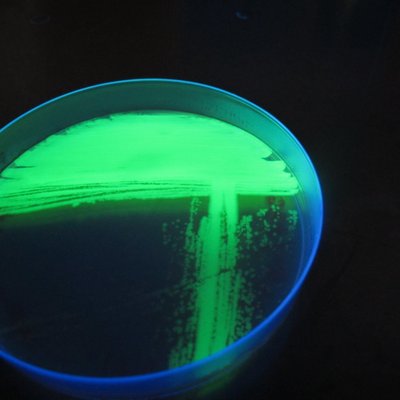
Profile Picture of Subhadeep Chatterjee (@Subhade68512667) on Twitter

Subhadeep Chatterjee, age 46, Seattle, WA View Details
Possible Relatives: Bishakha Chatterjee, Subroto Mukherjee, Paramita N Chatterjee
Subhadeep Chatterjee, age 46, Seattle, WA View Details
Possible Relatives: Bishakha Chatterjee, Subroto Mukherjee
Subhadeep Chatterjee, age 30s, Seattle, WA View Details
Locations: Seattle WA Possible Relatives: Pamela Chatterjee, Satyen N Chatterjee, Saurav Chatterjee
Subhadeep Chatterjee, age 73 View Details
Address:***** 42nd Ave Ne, Seattle, WA
Subhadeep N Chatterjee, age 45 View Details
Address:***** 13th Ave W, Seattle, WA. Phone Number: (206) 390-****
Subhadeep Chatterjee View Details
Address:***** Madison Ln, Apt F, Charlottesville, VA
Search locality history, phone, age and more.

Subhadeep Chatterjee • subhadeep.chatterjee1


Subhodeep Chatterjee • subhodeep.chatterjee.35


Subhajeet Chatterjee (Beuty chatterjee) • subhajeet.chatterjee.73


Chatterjee Subhodeep • cngcgr.subho


Suvradeep Chatterjee • suvradeep.chatterjee.182


Subhradeep Chatterjee (hrithik) • subhradeep.chatterjee.39


Shubhadip Chatterjee (Shubha) • shubhadip.chatterjee.96


Subhradeep Chatterjee (hrithik) • subhradeep.chatterjee.39


Súbhádèép Mûkhèrjêë • subhadeep.mukherjee.714655


Subhadeep Chakraborty • subhadeep.chakraborty.3110


Subhadeep Chattoraj • subhadeep.chattoraj


Subhadip Chatterjee • subhadip.chatterjee.395017


Subhadip Chatterjee • Subhadip-Chatterjee


Subhadeep Chattoraj • subhadeep.chattoraj.3


Subhadeep Chatterjee • __.subho__

Subhadeep Chatterjee • akash.chatterjee.1675

Subhadeep Chatterjee • certainly_not_a_human

Subhadeep Chatterjee • chatterjee.subhadeep

Subhadeep Chatterjee • itss_demon

Subhadeep Chatterjee • mysterious_shutterbug

Subhadeep Chatterjee • raasta_mahn

SUBHADEEP CHATTERJEE • subhadeep.c

Subhadeep Chatterjee • subhadeep.chatterjee

Subhadeep Chatterjee • subhadeep.chatterjee.14661

Subhadeep Chatterjee • subhadeep.chatterjee.330

Subhadeep Chatterjee • subhadeep.chatterjee.5

Subhadeep Chatterjee • subhadeep.jeet

Subhadeep Chatterjee • subhadeep.rivu

Subhadeep Chatterjee • subhadeep328

SUBHADEEP CHATTERJEE • subhadeep4

Subhadeep Chatterjee • subhadeep6003

Subhadeep Chatterjee • subhadeepchatterjee_99

Subhadeep chatterjee • suvomusicologist

Subhadeep CR7 Chatterjee.! • subhadeep_cr7_chatterjee

subhadip chatterjee... • subhadipc650

Subhadeep Chatterjee • Dipak212chat

SUBHADEEP CHATTERJEE • SUBHADE68129833

Subhadeep Chatterjee • Shuvo81164

Subhadeep Chatterjee • Subhade61242116

Subhadeep Chatterjee • Subhade99451199

Subhadeep Chatterjee • SubhadeepWw

Subhadeep Chatterjee • deepsubho19

Subhadeep Chatterjee • itsshubhadeep

Subhadeep Chatterjee • subhadeepc837

Subhadeep Chatterjee • subhadeepchat17

Subhadeep Chatterjee • twt_trojan
Subhadeep Chatterjee • Subhade68512667

Subhadeep Chatterjee • Subhade99090360

Subhadeep Chatterjee • subh240

Subhadeep Chatterjee • subha_papai

Subhadeep Chatterjee • subhadgp11

Subhadeep Akhil Chatterjee • Subhade45894034

Subhadeep Chatterjee • chatterjee0812

Subhadeep Chatterjee • suby95

subhadeep chatterjee • subhadeepchatterjee612

Subhadeep Chatterjee • love_gablu

Subhadeep chatterjee • Subhadeep Chatterjee

subhadeep.chatterjee • subhadeep.chatterjee

Subhadeep Chatterjee • 186414113

Subhadeep Chatterjee • 330611828

Subhadeep Chatterjee • 340026361

Subhadeep Chatterjee • deepseaturtle

Subhradeep Chatterjee • 233937793

Subhadip Chatterjee • 193159777

Subhadeep Chatterjee is an Indian molecular biologist and a scientist at the Centre for DNA Fingerprinting and Diagnostics (CDFD). A member of Guha Research Conference, he is known for his studies on read more...
Subhadeep Chatterjee Needs Food / Meal In Seattle, WA ...
us.sulekha.com › seattle-wa › food-meal-catering › subhadeep-chatterjee-needs-food-meal-in-seattle-wa-1515262
en.wikipedia.org › wiki › Sanjeev_Das
mytaj.ihcltata.com › HRMSWeb › MyDashboard › Index
Amitabha Mukhopadhyay - Wikipedia
en.wikipedia.org › wiki › Amitabha_Mukhopadhyay
Phytopathology Journal: First Look - APS Publications
apsjournals.apsnet.org › toc › phyto › ja
What's Subhadeep Chatterjee's Instagram?
We've discovered several social media accounts associated with Subhadeep Chatterjee, including @mysterious_shutterbug, @__.subho__, @itss_demon, @subhadeep_cr7_chatterjee and others. To explore more of Subhadeep Chatterjee's online presence, click here.
What's Subhadeep Chatterjee's Facebook?
We've discovered several social media accounts associated with Subhadeep Chatterjee, including @subhadeep.chatterjee1, @subhodeep.chatterjee.35, @subhajeet.chatterjee.73, @cngcgr.subho and others. To explore more of Subhadeep Chatterjee's online presence, click here.
What's Subhadeep Chatterjee's famous for?
Subhadeep Chatterjee is an Indian molecular biologist and a scientist at the Centre for DNA Fingerprinting and Diagnostics (CDFD). A member of Guha Research Conference, he is known for his studies on plant-microbe interactions and heads the Lab of Plant-Microbe Interactions at CDFD where he hosts several researchers.. You can find more here.
Are PeekYou social results accurate?
PeekYou is a free people-focused search engine that uncovers information typically buried by other search engines. Its clean and user-friendly format makes it easy to navigate. The platform offers accurate data and conveniently links to an individual's social media profiles and other public websites with which they are associated.